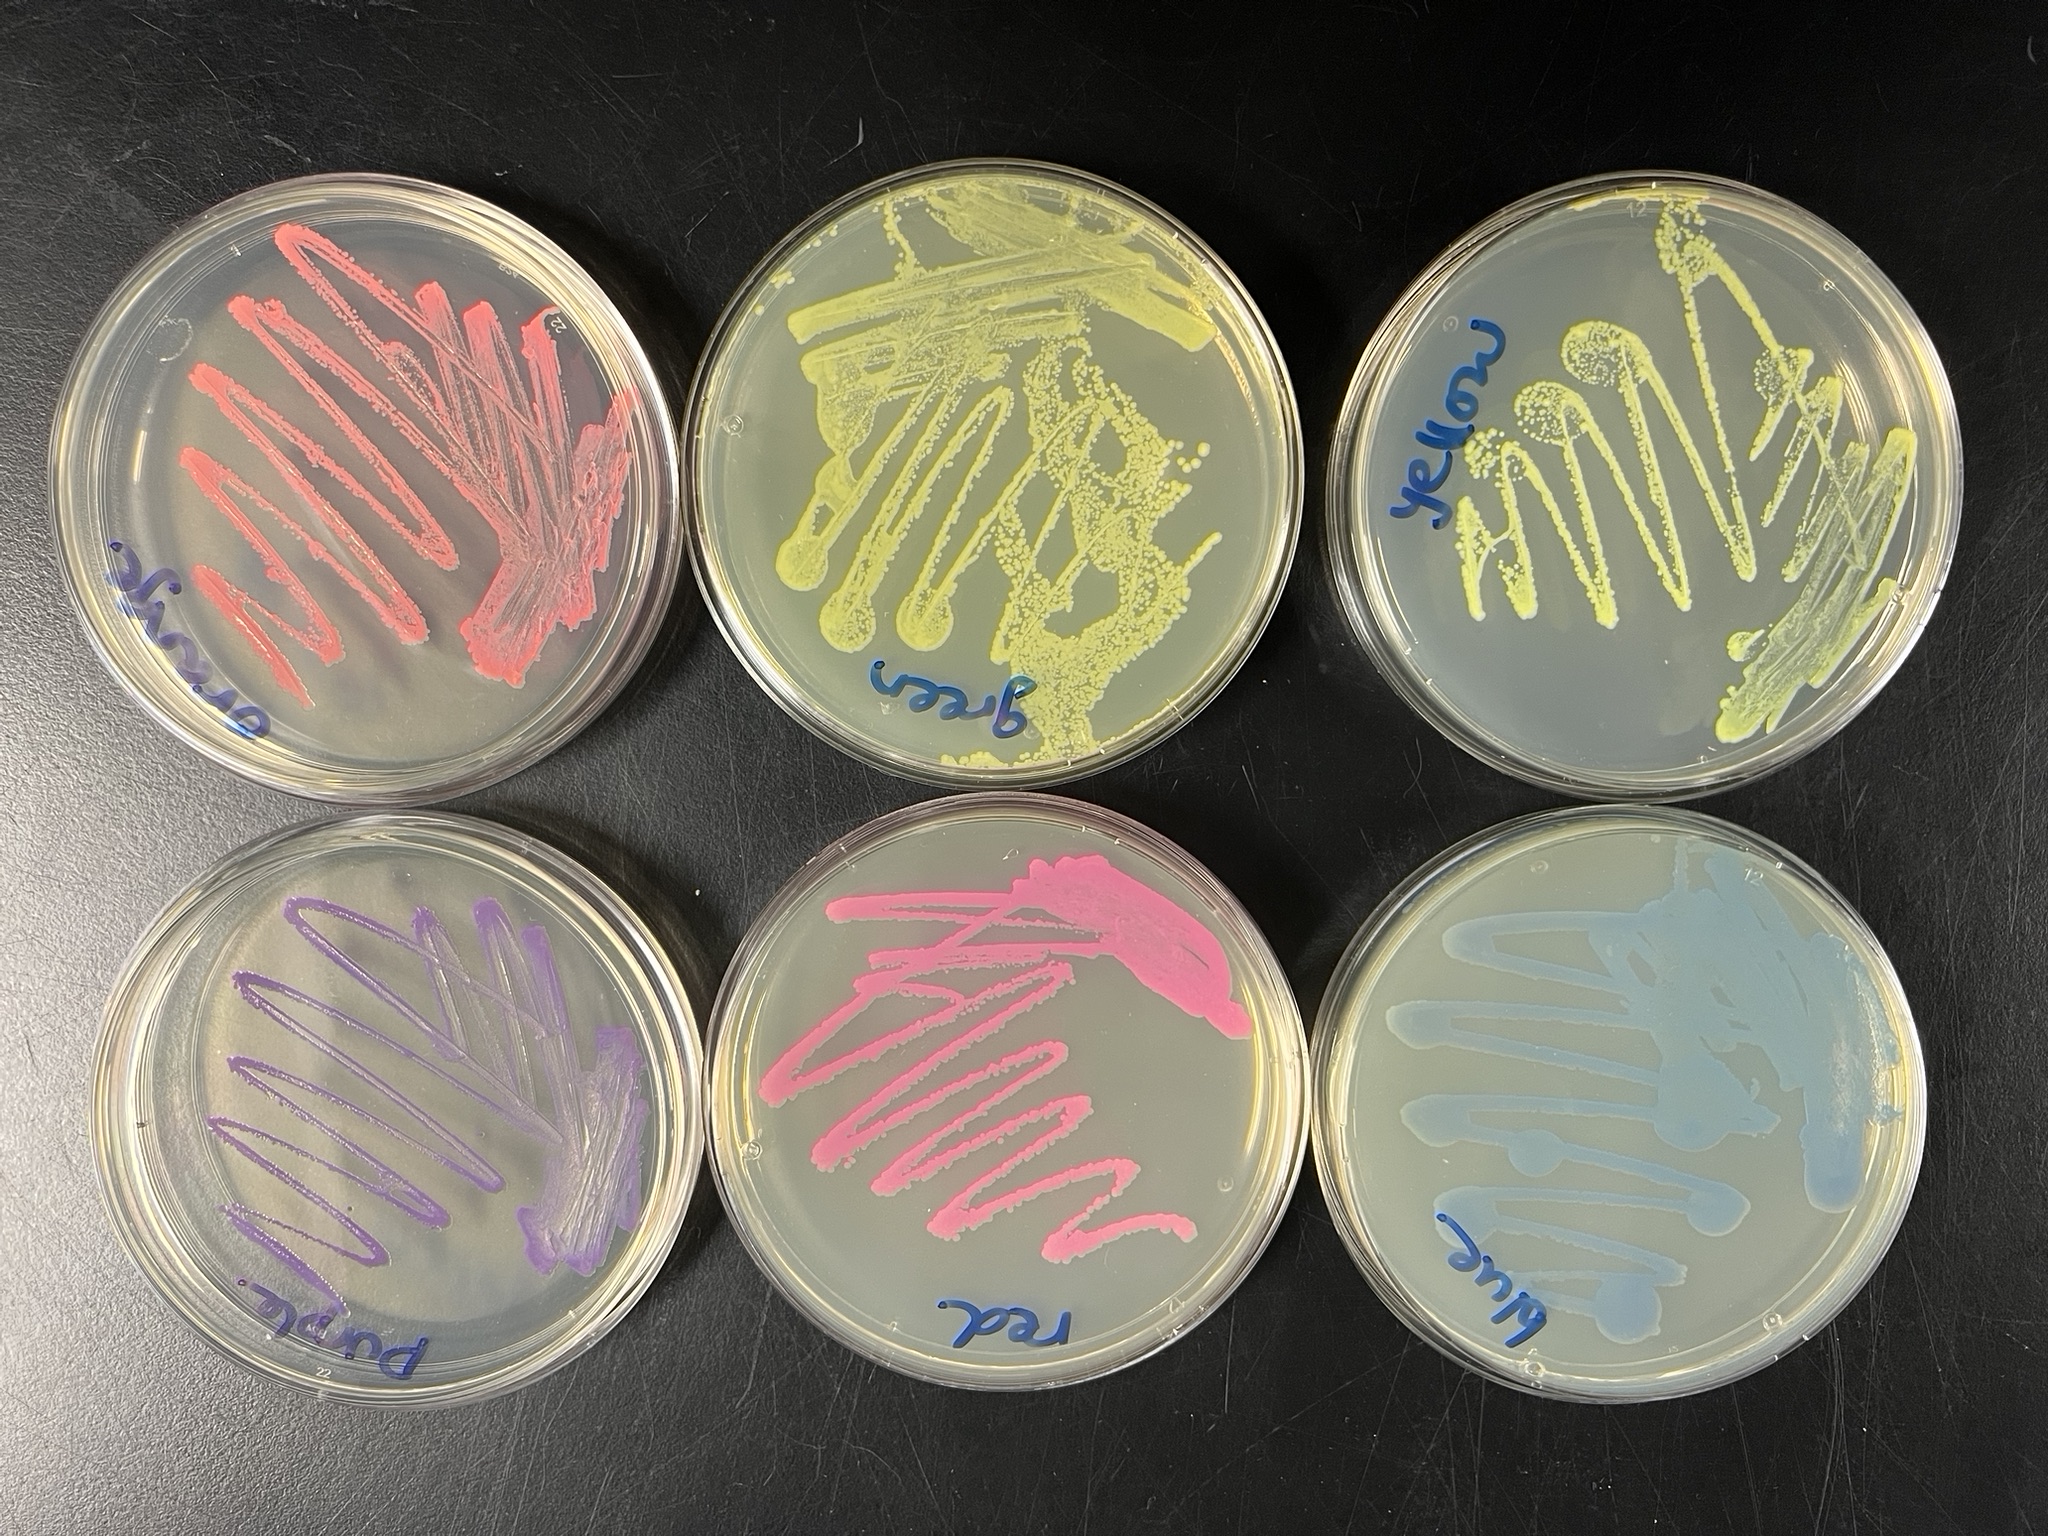
cover image
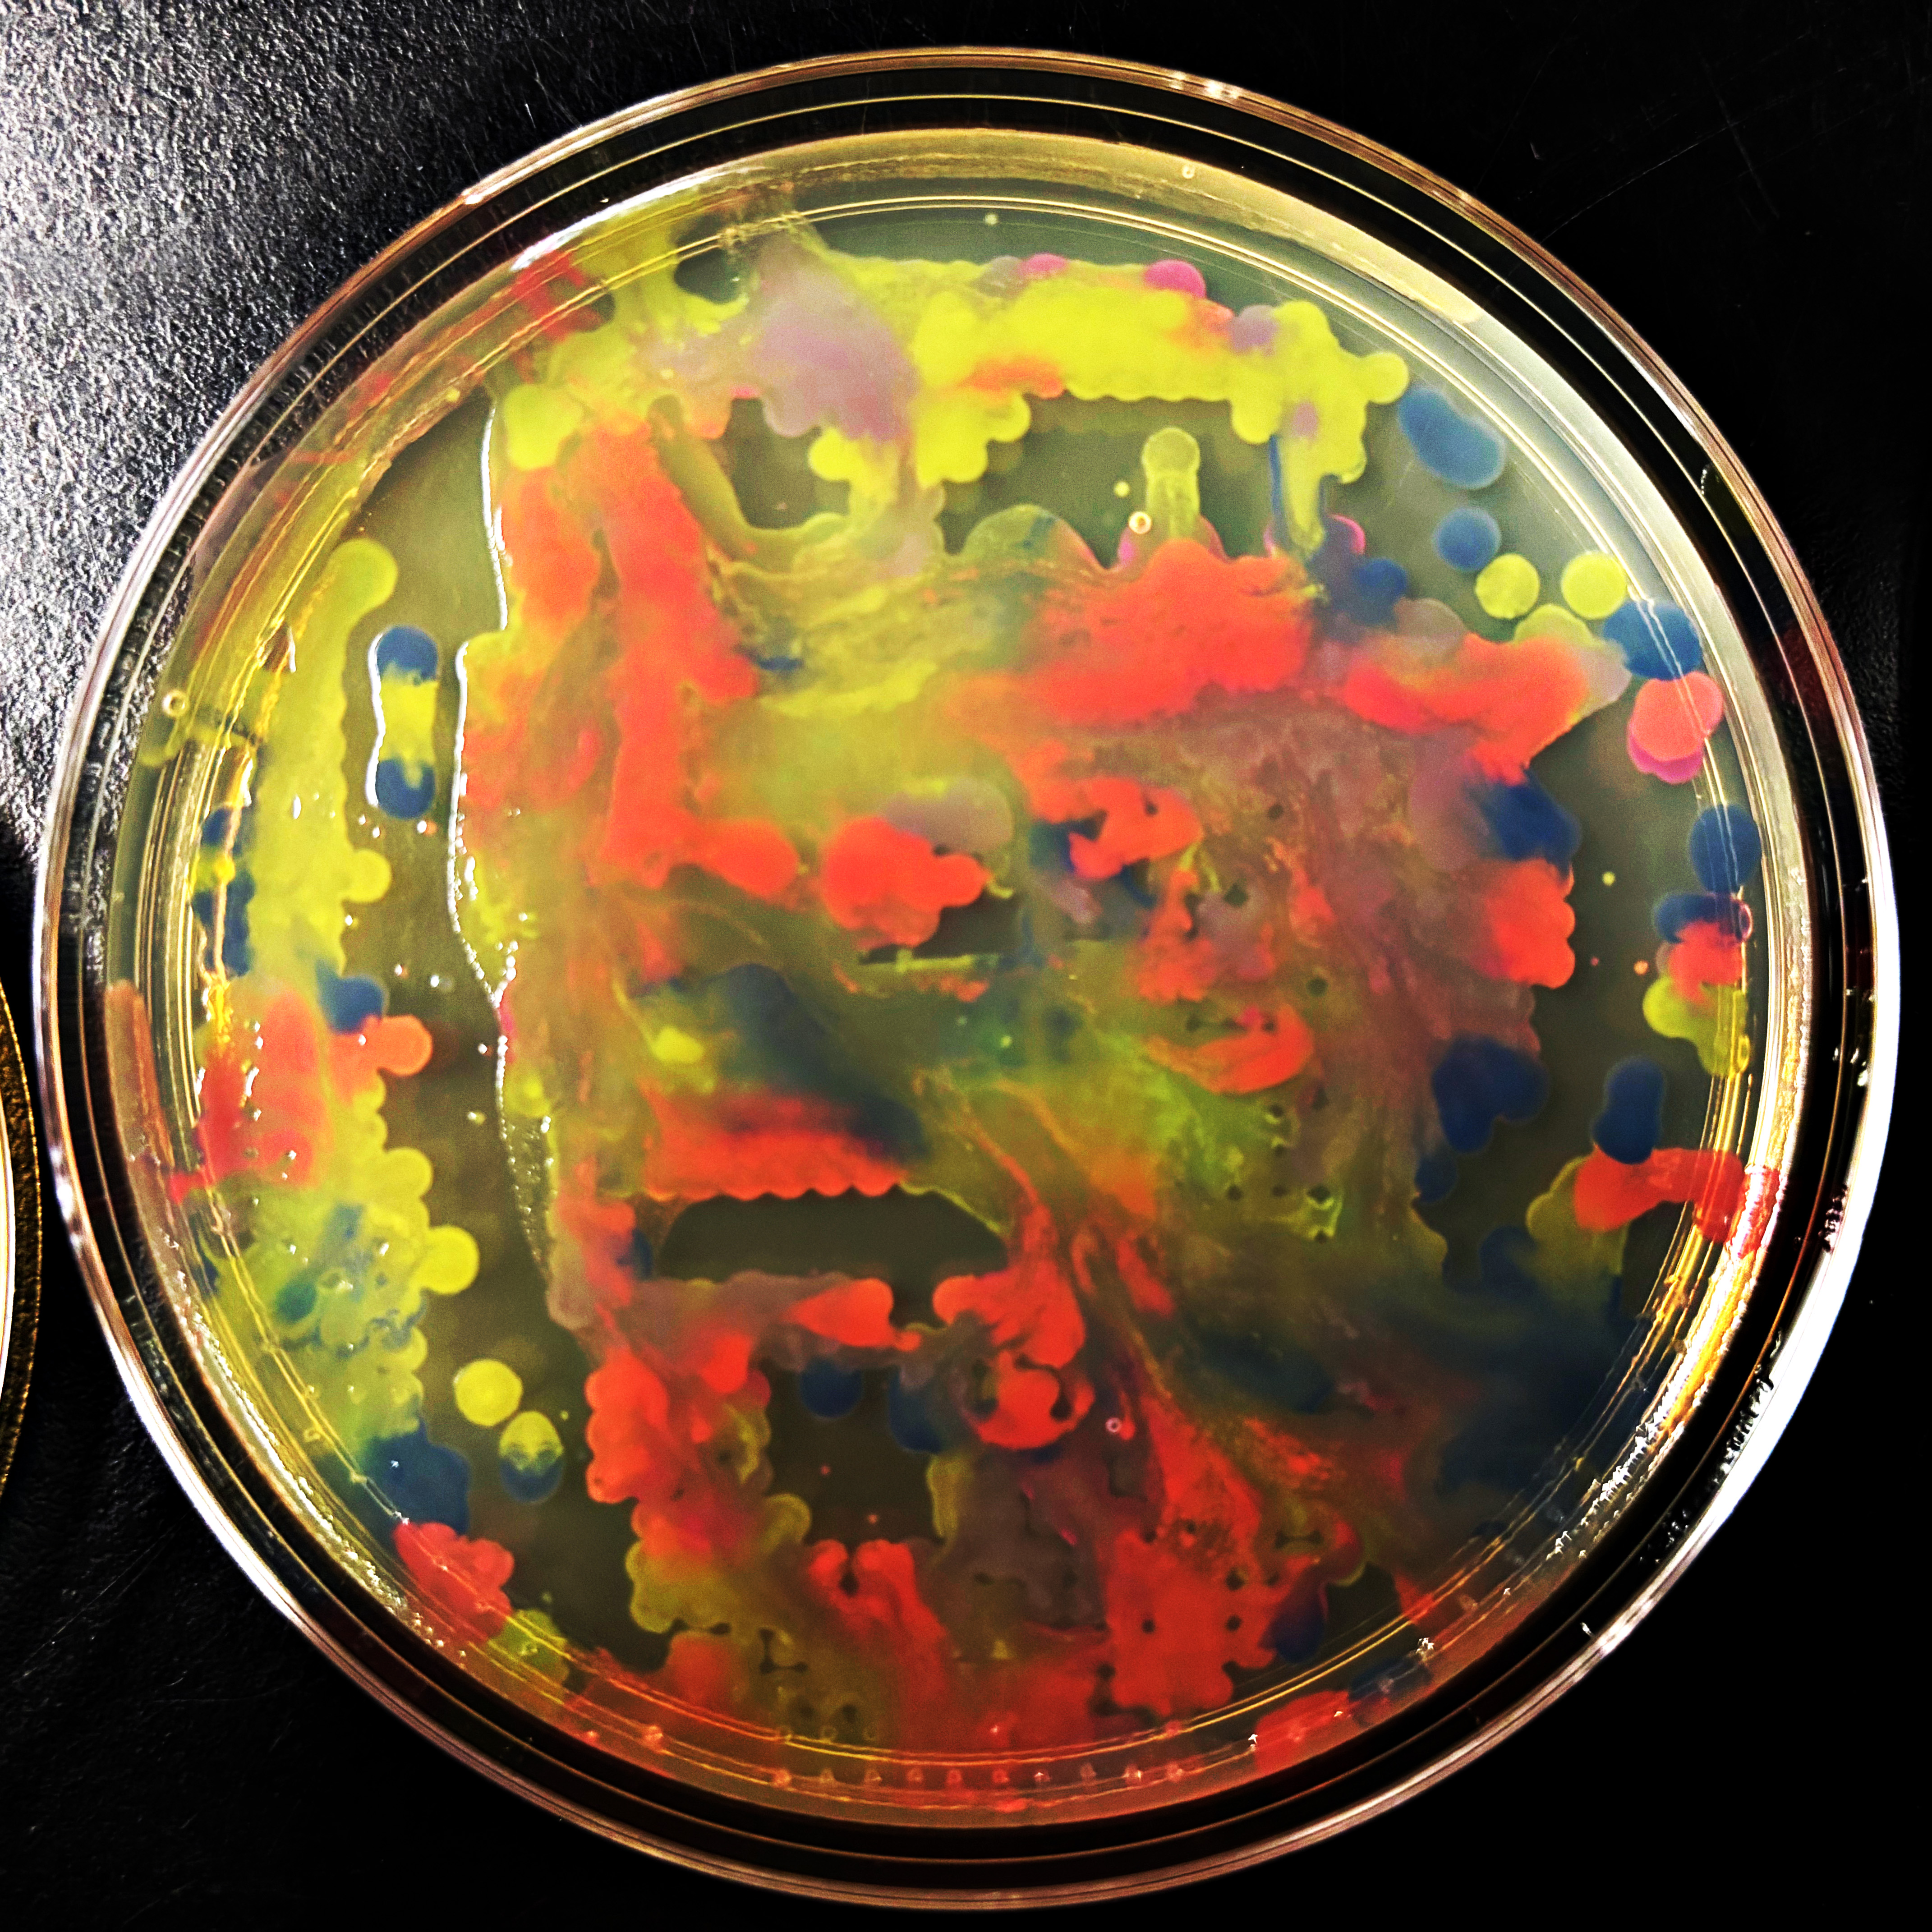
cover image

Week 3 HW: Lab Automation

Part 1: Generate an artistic design
NOTE: Some of my newer and hopefully maybe better images are toward the end!
I generated the above artistic design – a self portrait – using the GUI at opentrons-art.rcdonovan.com – NOTE: BUGSS Lab has colors: orange, green, yellow, purple, red, blue
A below is me working on simulating that, redrawing and recoloring little bit in the Google Colab notebok with the six colors at BUGSS Lab. Thanks to Amanda and everyone for helping hack up that code.

And below this is the photo of the six colors at BUGSS Lab:
And then below this is my self-portrait trying to get closer to those colors:

And below this is me working in the google colab notebook to make symmetrical multicolor designs. This is me drawing directly with google colab python code, rather than importing code from Ronan’s website.

Updated Feb 21: Here is a new self-portrait, closer up, with less flat areas of color, in a screenshot from the Google Colab notebok:

Also updated Feb 21: Here is that same new self-portrait, trying to simulate the six colors at BUGSS Lab:

OK! Last set of uopdates before lab! Here is myabe my best, trying to hit the sweet spot of everything I did so far. Her eon Ronan’s site:

That with saturated colors in the google colab:

And finally that trying to simulate colors in the photo from BUGSS Lab:

And, update March 9! Here is a photo our awesome TA Joel Tyson took, who said “messing with the opentrons a little. Here are some runs I tried with Eric’s design w 0.2ul drops. I also put a pause between drops to see if it helps dry it.” Thanks, Joel!